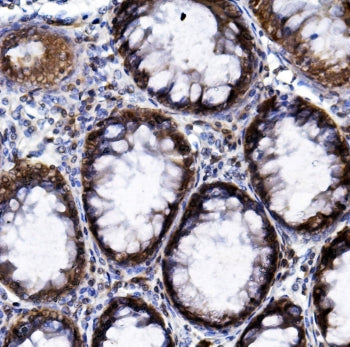
HIF1A Antibody / HIF-1 alpha

NSJ Bioreagents
SKU:RQ5734
HIF1A Antibody / HIF-1 alpha
HIF1A Antibody / HIF-1 alpha
Couldn't load pickup availability
HIF-1a (Hypoxia-inducible factor 1a, HIF1A) is a transcription factor that mediates cellular and systemic homeostatic responses to reduced O2 availability in mammals, including angiogenesis, erythropoiesis and glycolysis. This gene was mapped to 14q21-q24. HIF-1a transactivate genes required for energy metabolism and tissue perfusion and is necessary for embryonic development and tumor explant growth. HIF-1alpha is over expressed during carcinogenesis, myocardial infarction and wound healing. It is crucial for the cellular response to hypoxia and is frequently over expressed in human cancers, resulting in the activation of genes essential for cell survival. HIF-1a regulates the survival and function in the inflammatory microenvironment directly. It is a transcription factor that plays a pivotal role in cellular adaptation to changes in oxygen availability.
Share